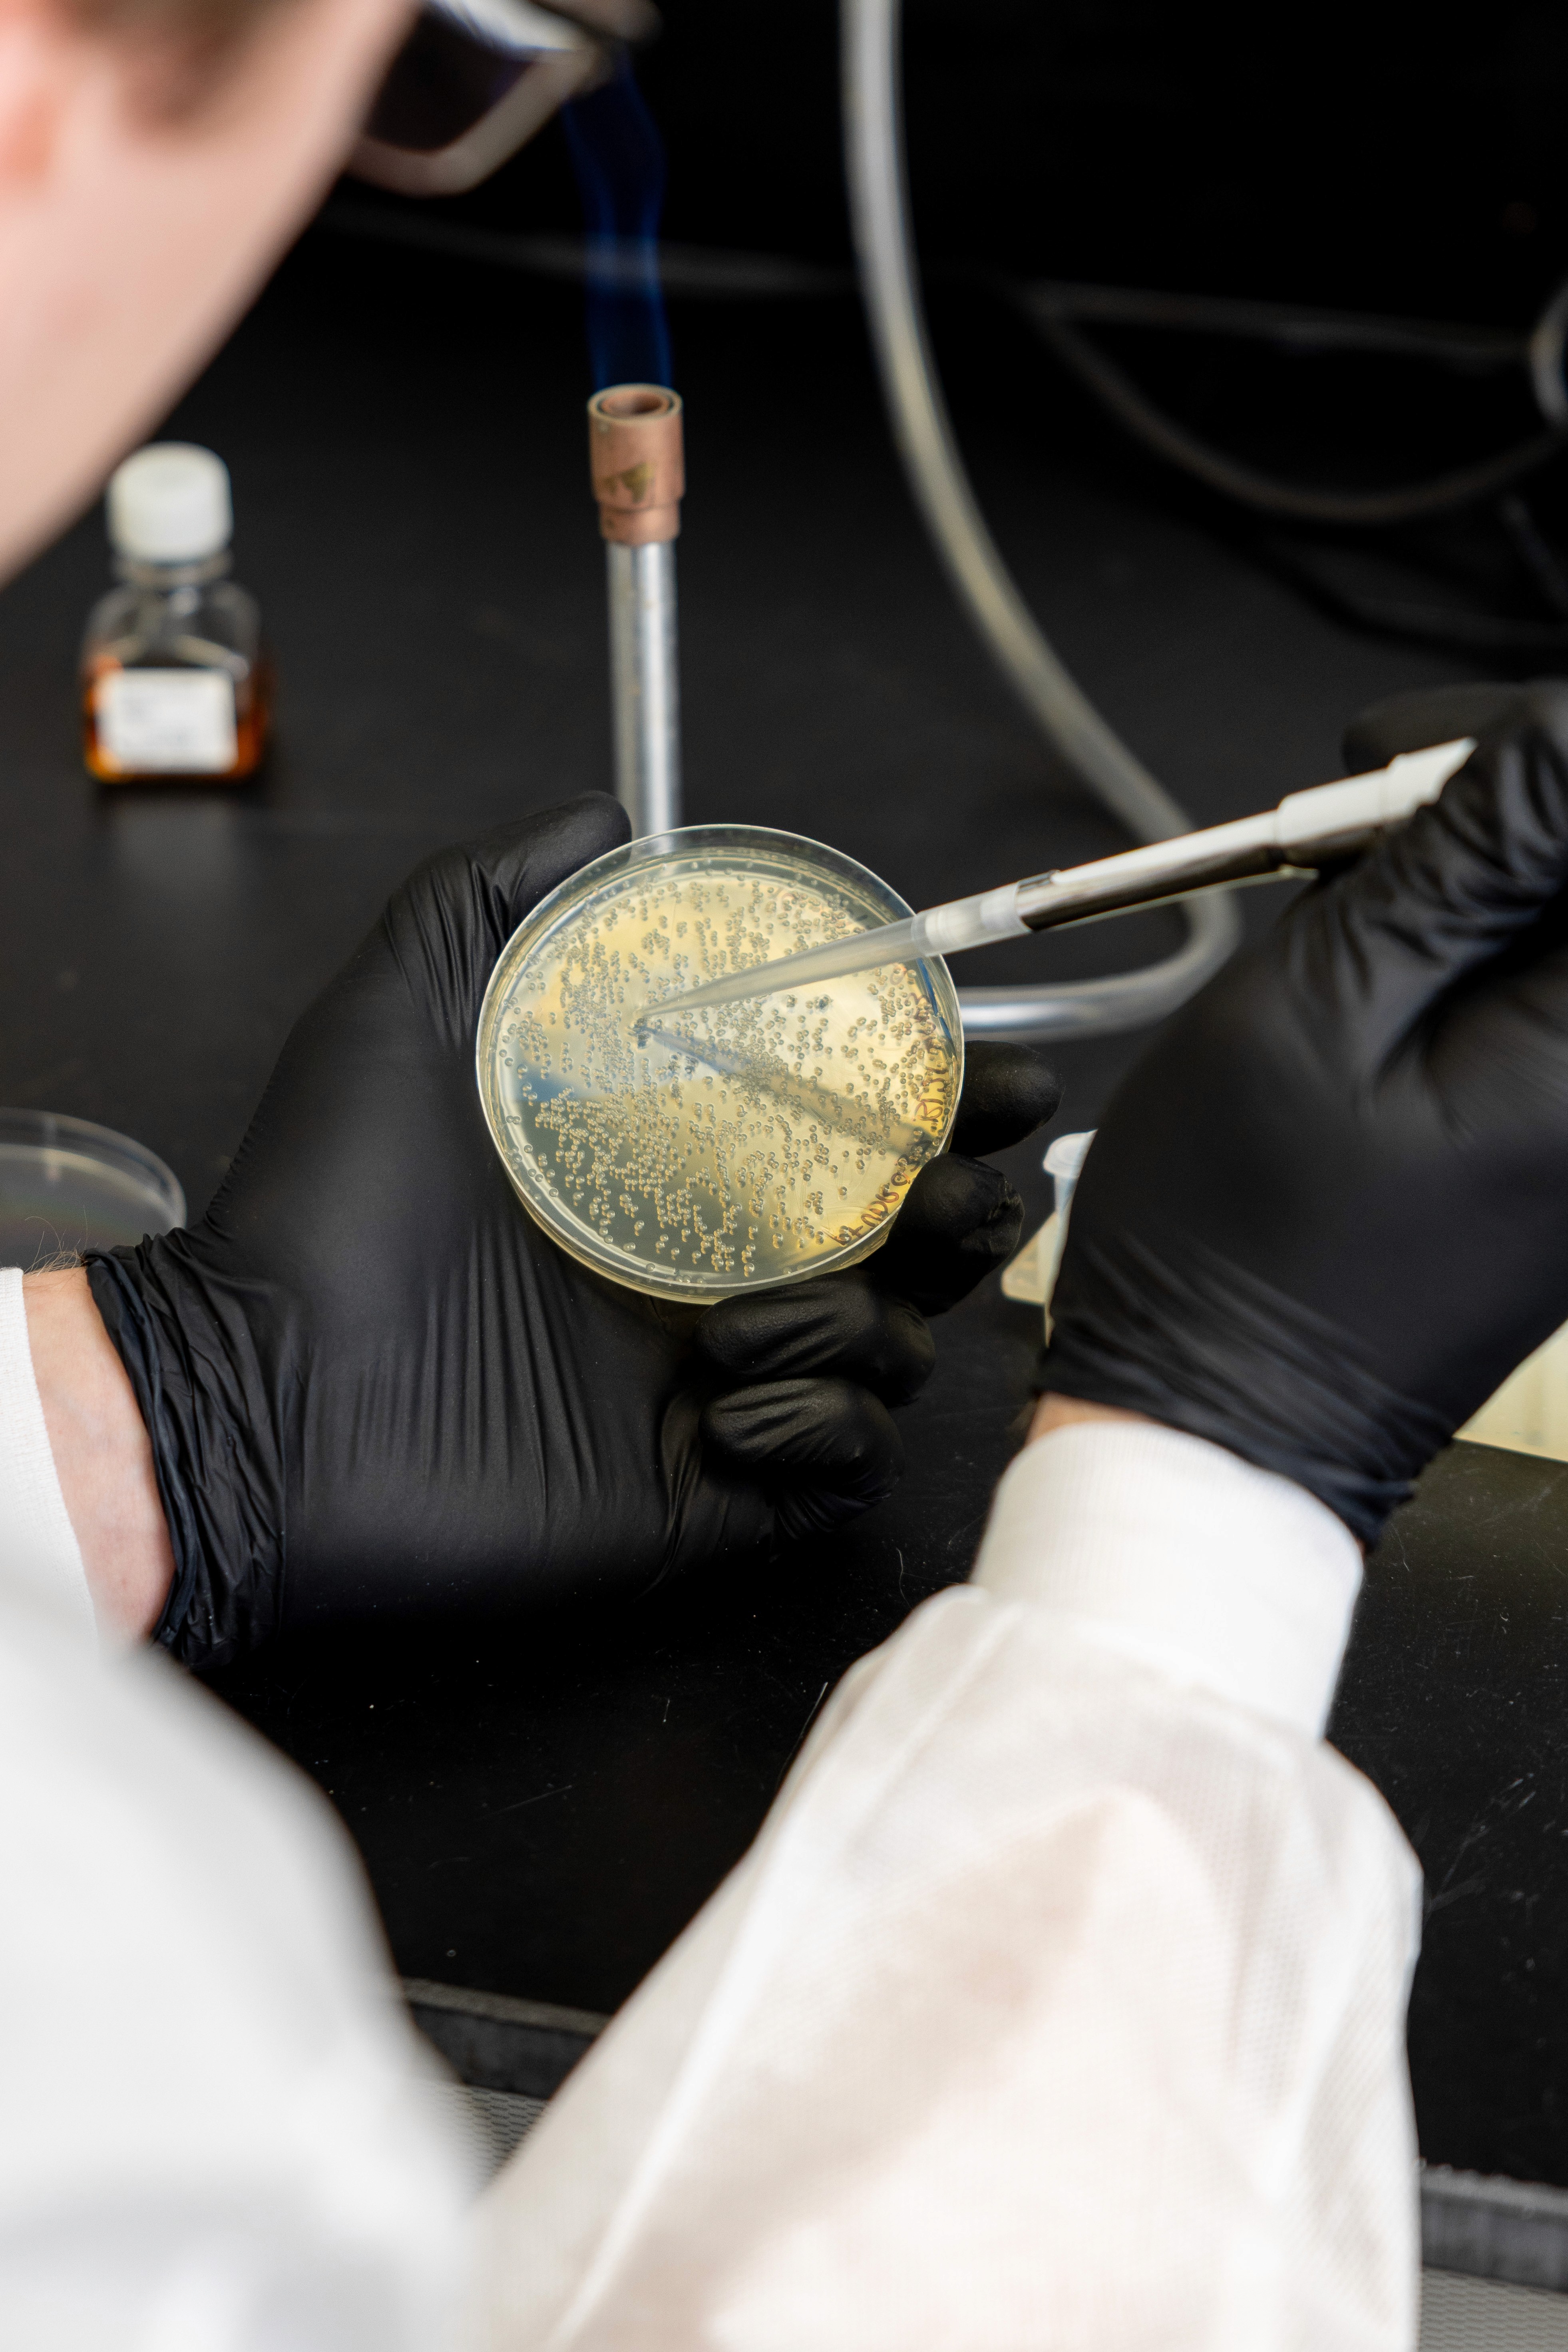

Ask about our free Pilot2Partnership program
Learn more
Partnership Program
Pilot2Partnership™ Program
Pilot2Partnership™ is a no-cost pilot program designed for teams moving toward bulk or recurring protein production.
The idea is simple: we’ll take the first step and perform a free R&D pilot production of your protein, so you can decide based on data—not promises.

Services
Contract Manufacturing Services
Consistent. Scalable. CLīM™-Powered.
Whether you're scaling a proven enzyme or developing a novel target, TriAltus delivers high-purity, high-performance proteins at production scale—backed by ISO 13485- compliant manufacturing and the unmatched efficiency of our CL7/Im7 affinity system.
Our contract manufacturing services are designed to support both catalog enzymes and custom targets with flexible volumes and formulations, validated batch testing, and cost advantages that scale with you.


Process
Order online or request a custom Enzyme through our Pilot2Partnership™ program.
Ordering is simple:
Need Bulk of a Catalog Enzyme?
Use the Buy in Bulk button on any product page to request a custom quote. We offer scalable pricing, lot-specific QC, and secure supply.
Need a Custom Enzyme?
Our team adapts your sequence to our CLīM™ system and develops a custom production protocol—for free—through our Pilot2Partnership™ program. Once validated, we transition seamlessly into long-term supply.
Capabilities and Add on Services
TriAltus Capabilities
ISO13485-compliant manufacturing
Strict regulatory compliance for diagnostic-grade proteins.
Custom formulation and packaging
Tailored formulations and packaging designed for downstream applications.
Flexible scale from 10 mg to >100 g
Scalable production to match both research and commercial requirements.
Add on services
Protein engineering
Custom-engineered proteins optimized for performance and function.
Solubility screening
Rapid screening to identify optimal solubility conditions.
Enzymatic assays: activity or other QC
Validated assays to confirm protein activity and quality.
Mass Spec analysis
Detailed molecular characterization with advanced mass spectrometry.
HPLC-SEC
High-resolution size exclusion chromatography for purity assessment.
Lyophilization
Stable, long-term storage with expert freeze-drying solutions.

